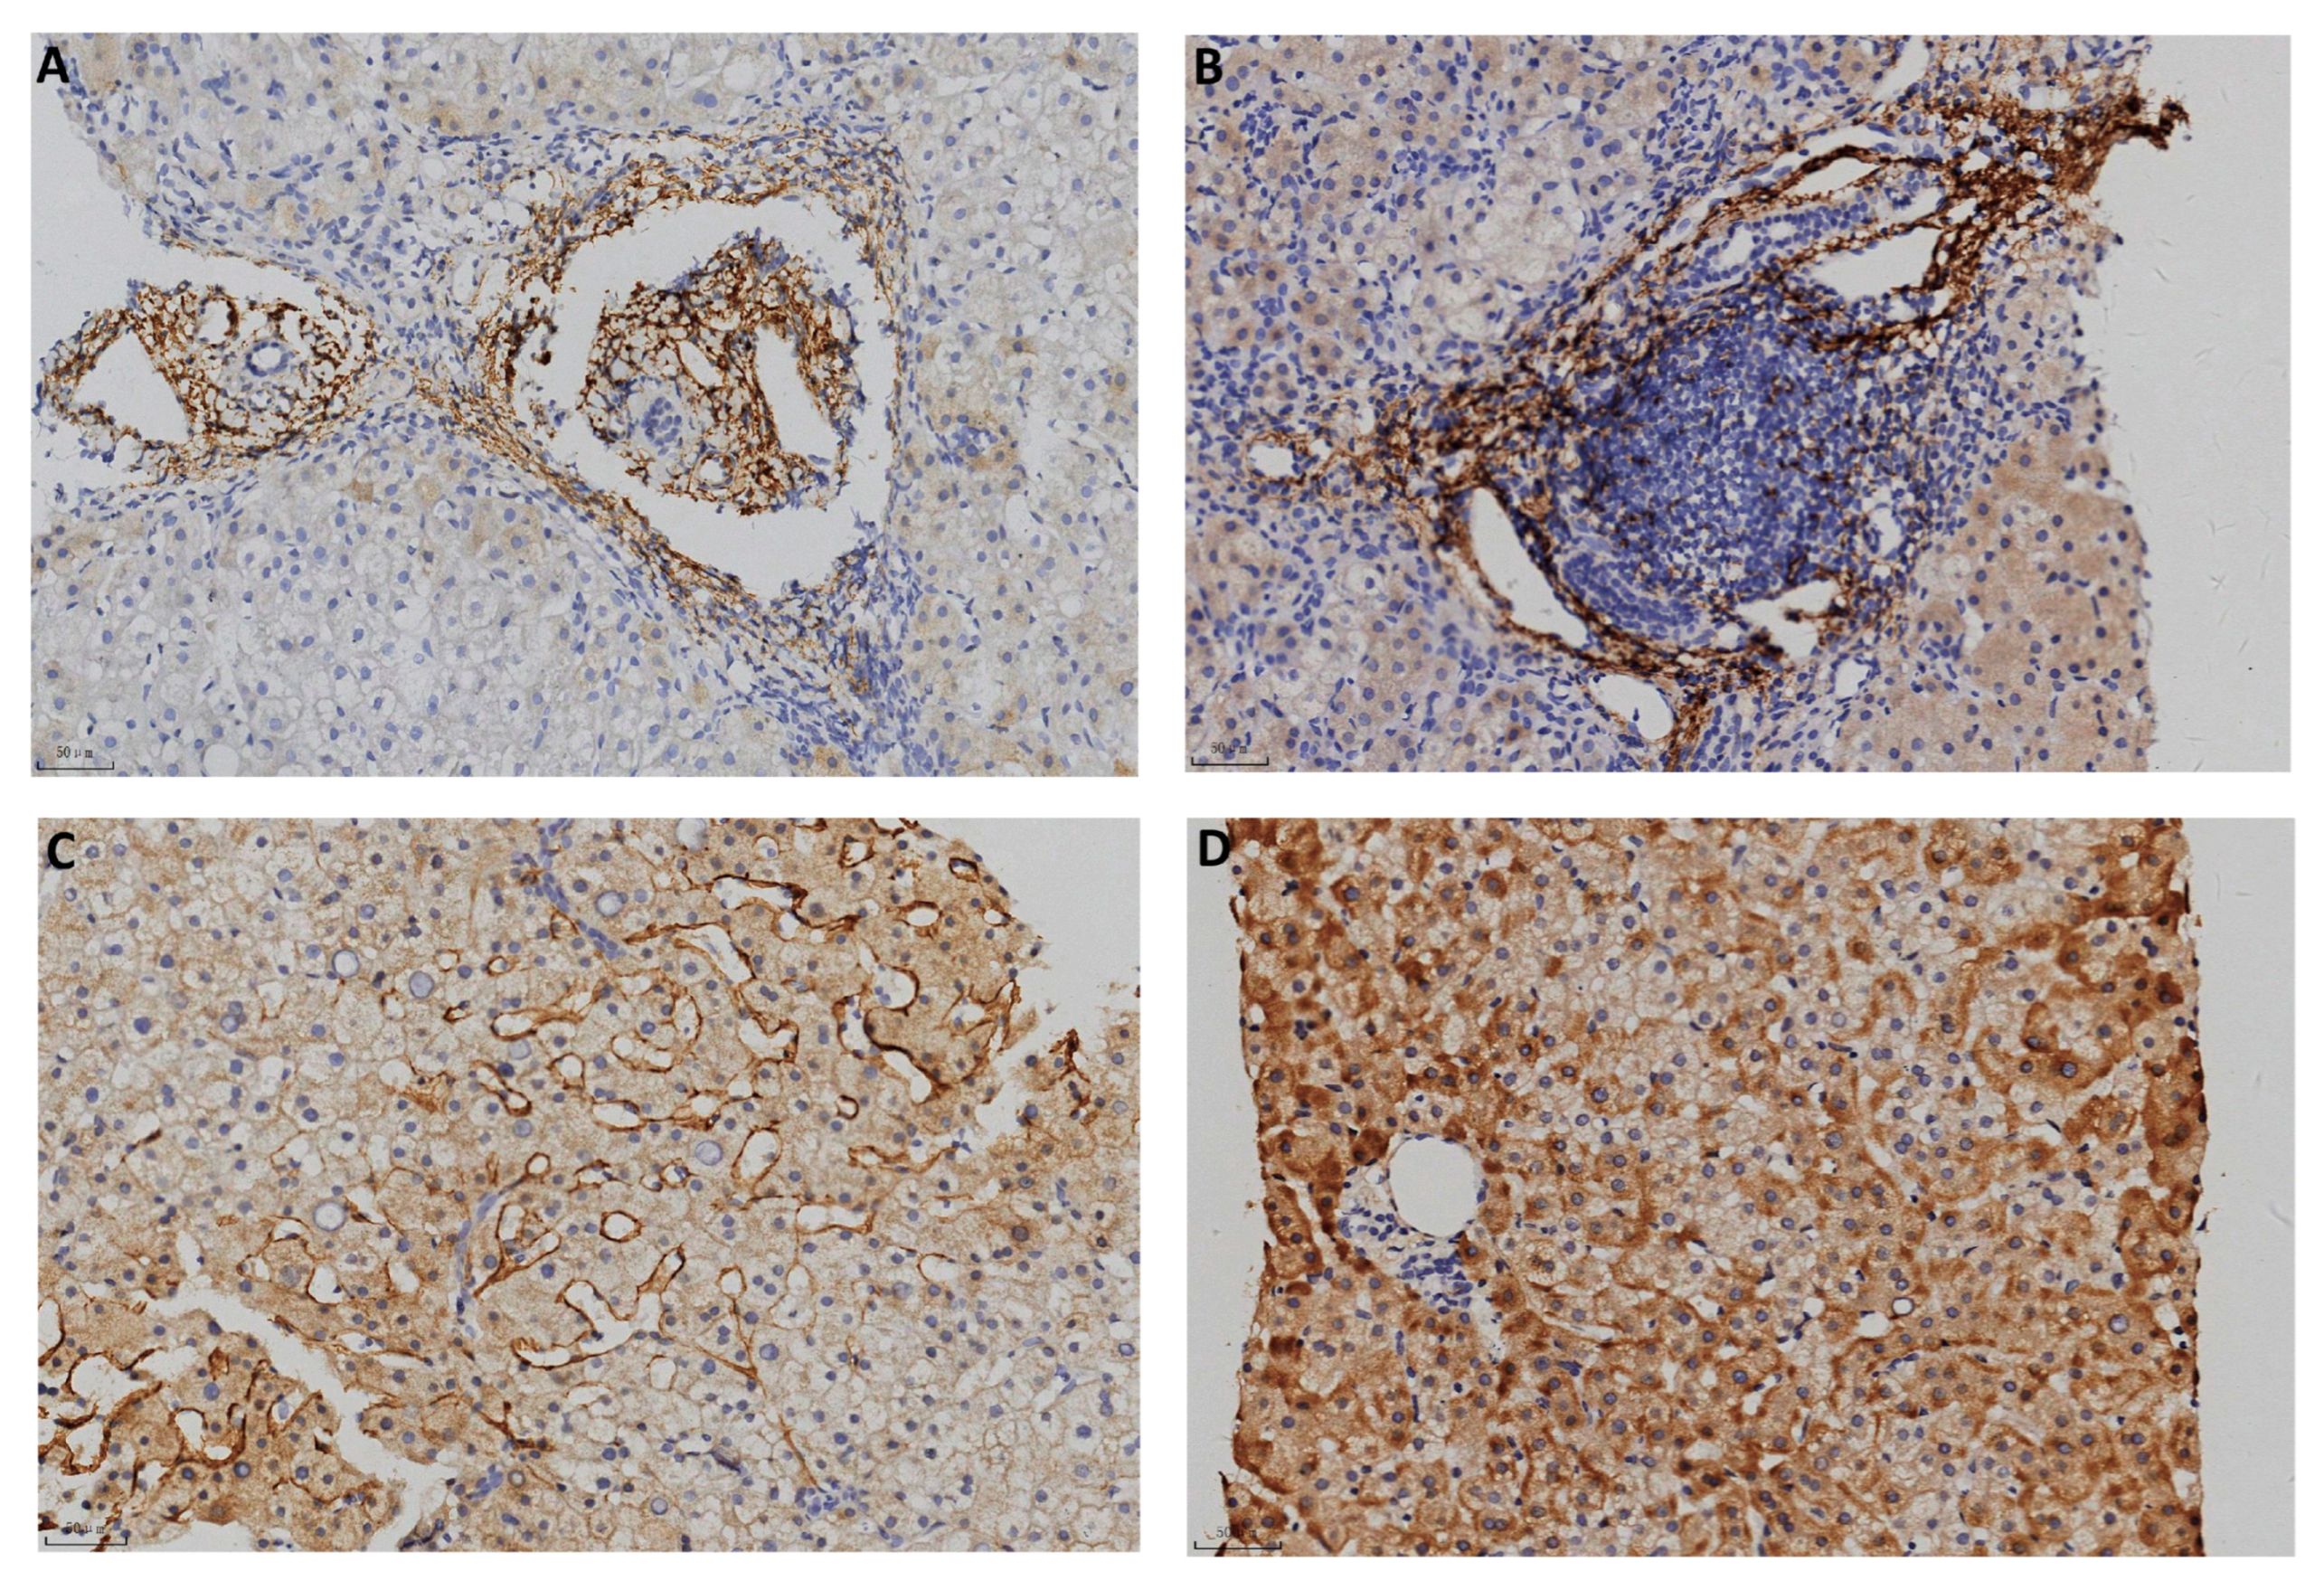
Pathophysiology 32 00030 g002

C4d Immunoreactivity in Autoimmune and HBV-Induced Hepatitis: Implications for Complement-Mediated Hepatocellular Injury
Abstract
1. Introduction
2. Materials and Methods
2.1. Patients and Specimens
2.2. Immunohistochemistry (IHC)
2.3. Pathologic Evaluation
2.4. Statistics
3. Results
4. Discussion and Conclusions
Supplementary Materials
Author Contributions
Funding
Institutional Review Board Statement
Informed Consent Statement
Data Availability Statement
Conflicts of Interest
References
- Lazar, S.; Kahlenberg, J.M. Systemic Lupus Erythematosus: New Diagnostic and Therapeutic Approaches. Annu. Rev. Med. 2023, 74, 339–352. [Google Scholar] [CrossRef] [PubMed]
- Terziroli Beretta-Piccoli, B.; Mieli-Vergani, G.; Vergani, D. Autoimmmune hepatitis. Cell. Mol. Immunol. 2022, 19, 158–176. [Google Scholar] [CrossRef]
- Biewenga, M.; Farina Sarasqueta, A.; Tushuizen, M.E.; de Jonge-Muller, E.S.M.; van Hoek, B.; Trouw, L.A. The role of complement activation in autoimmune liver disease. Autoimmun. Rev. 2020, 19, 102534. [Google Scholar] [CrossRef]
- Bouron-Dal Soglio, D.; Rougemont, A.-L.; Herzog, D.; Soucy, G.; Alvarez, F.; Fournet, J.-C. An immunohistochemical evaluation of C4d deposition in pediatric inflammatory liver diseases. Hum. Pathol. 2008, 39, 1103–1110. [Google Scholar] [CrossRef]
- Dammacco, F.; Sansonno, D. Therapy for hepatitis C virus-related cryoglobulinemic vasculitis. N. Engl. J. Med. 2013, 369, 1035–1045. [Google Scholar] [CrossRef] [PubMed]
- Trepo, C.G.; Zucherman, A.J.; Bird, R.C.; Prince, A.M. The role of circulating hepatitis B antigen/antibody immune complexes in the pathogenesis of vascular and hepatic manifestations in polyarteritis nodosa. J. Clin. Pathol. 1974, 27, 863–868. [Google Scholar] [CrossRef]
- Bai, L.; Zhang, X.; Kozlowski, M.; Li, W.; Wu, M.; Liu, J.; Chen, L.; Zhang, J.; Huang, Y.; Yuan, Z. Extracellular Hepatitis B Virus RNAs Are Heterogeneous in Length and Circulate as Capsid-Antibody Complexes in Addition to Virions in Chronic Hepatitis B Patients. J. Virol. 2018, 92. [Google Scholar] [CrossRef] [PubMed]
- Tang, Y.; Xu, M.; Wang, C.; Wu, M.; Hu, L.; Li, J.; Lu, W.; Zheng, Y.; Zhang, M.; Jiang, X.; et al. Circulating capsid-antibody-complexes (CACs) drive intrahepatic complement deposition and inform subclinical liver inflammation in chronic hepatitis B. Antivir. Res. 2024, 231, 106017. [Google Scholar] [CrossRef] [PubMed]
- Zhang, C.; Li, J.; Cheng, Y.; Meng, F.; Song, J.W.; Fan, X.; Fan, H.; Li, J.; Fu, Y.L.; Zhou, M.J.; et al. Single-cell RNA sequencing reveals intrahepatic and peripheral immune characteristics related to disease phases in HBV-infected patients. Gut 2023, 72, 153–167. [Google Scholar] [CrossRef]
- Feucht, H.E.; Felber, E.; Gokel, M.J.; Hillebrand, G.; Nattermann, U.; Brockmeyer, C.; Held, E.; Riethmüller, G.; Land, W.; Albert, E. Vascular deposition of complement-split products in kidney allografts with cell-mediated rejection. Clin. Exp. Immunol. 1991, 86, 464–470. [Google Scholar] [CrossRef]
- Sapir-Pichhadze, R.; Curran, S.P.; John, R.; Tricco, A.C.; Uleryk, E.; Laupacis, A.; Tinckam, K.; Sis, B.; Beyene, J.; Logan, A.G.; et al. A systematic review of the role of C4d in the diagnosis of acute antibody-mediated rejection. Kidney Int. 2015, 87, 182–194. [Google Scholar] [CrossRef] [PubMed]
- Cohen, D.; Colvin, R.B.; Daha, M.R.; Drachenberg, C.B.; Haas, M.; Nickeleit, V.; Salmon, J.E.; Sis, B.; Zhao, M.H.; Bruijn, J.A.; et al. Pros and cons for C4d as a biomarker. Kidney Int. 2012, 81, 628–639. [Google Scholar] [CrossRef] [PubMed]
- Fayek, S.A. The value of C4d deposit in post liver transplant liver biopsies. Transpl. Immunol. 2012, 27, 166–170. [Google Scholar] [CrossRef]
- Lee, M. Antibody-Mediated Rejection After Liver Transplant. Gastroenterol. Clin. N. Am. 2017, 46, 297–309. [Google Scholar] [CrossRef]
- Qin, S.; Wang, X.; Wang, J.; Wu, H. Complement C4d as a biomarker for systemic lupus erythematosus and lupus nephritis. Lupus 2024, 33, 111–120. [Google Scholar] [CrossRef]
- Vlaicu, S.I.; Tatomir, A.; Cuevas, J.; Rus, V.; Rus, H. COVID, complement, and the brain. Front. Immunol. 2023, 14, 1216457. [Google Scholar] [CrossRef] [PubMed]
- Wang, H.; Liu, M. Complement C4, Infections, and Autoimmune Diseases. Front. Immunol. 2021, 12, 694928. [Google Scholar] [CrossRef] [PubMed]
- Ma, X. Guidelines on the diagnosis and management of autoimmune hepatitis (2021). J. Clin. Hepatol. Linchuang Gandanbing Zazhi 2022, 38, 42–49. [Google Scholar] [CrossRef]
- Desmet, V.J.; Gerber, M.; Hoofnagle, J.H.; Manns, M.; Scheuer, P.J. Classification of chronic hepatitis: Diagnosis, grading and staging. Hepatology 1994, 19, 1513–1520. [Google Scholar] [CrossRef]
- Zhang, X.; Lu, W.; Zheng, Y.; Wang, W.; Bai, L.; Chen, L.; Feng, Y.; Zhang, Z.; Yuan, Z. In Situ analysis of intrahepatic virological events in chronic hepatitis B virus infection. J. Clin. Investig. 2016, 126, 1079–1092. [Google Scholar] [CrossRef]
- Montanari, N.R.; Ramirez, R.; Aggarwal, A.; van Buuren, N.; Doukas, M.; Moon, C.; Turner, S.; Diehl, L.; Li, L.; Debes, J.D.; et al. Multi-parametric analysis of human livers reveals variation in intrahepatic inflammation across phases of chronic hepatitis B infection. J. Hepatol. 2022, 77, 332–343. [Google Scholar] [CrossRef] [PubMed]
- Bugdaci, M.S.; Alkim, C.; Karaca, C.; Kesici, B.; Bayraktar, B.; Sokmen, M. Could complement C4 be an alternative to biopsy for chronic hepatitis B histopathologic findings? J. Clin. Gastroenterol. 2011, 45, 449–455. [Google Scholar] [CrossRef] [PubMed]
- Zhang, X.; Tang, Y.; Wu, M.; Wang, C.; Hu, L.; Zhang, Z. The Origin of Capsid-Derived Immune Complexes and Their Impact on HBV-Induced Liver Diseases. Viruses 2022, 14, 2766. [Google Scholar] [CrossRef] [PubMed]

| Inflammatory Liver Disease | Autoimmune Hepatitis | Chronic Hepatitis B |
|---|---|---|
| No. of biopsies | 15 | 72 |
| Gender (Male/Female) | 1:14 | 34:38 |
| Age (years) * | 57 (56, 64) | 41 (33, 49.75) |
| ALT (IU/L) * | 123 (35, 137) | 38 (24.25, 80) |
| C4d-positive biopsies n (%) | 11 (73.3) | 61 (84.7) |
| Portal area n (%) | 10 (66.7) | 58 (80.6) |
| Centrolobular vein n (%) | 1 (0.07) | 4 (5.6) |
| Hepatic sinusoid n (%) | 2 (0.13) | 11 (15.3) |
| Hepatic parenchyma n (%) | 0 | 9 (12.5) |
| Chronic Hepatitis B | C4d Deposition | p Value | |
|---|---|---|---|
| Negative | Postive | ||
| No. of biopsies | 11 | 61 | |
| Gender (Male/Female) | 3:8 | 31:30 | 0.35 1 |
| Age (years) | 38 (33, 47) | 41 (33, 50) | 0.70 2 |
| ALT (IU/L) * | 25 (14, 51) | 40 (25, 97.5) | 0.02 3 |
| Serum HBsAg (log10 IU/mL) | 3.66 (2.19, 4.17) | 3.55 (2.98, 3.96) | 0.87 3 |
| Serum HBeAg (S/CO) | 0.56 (0.42, 0.62) | 0.67 (0.42, 473.8) | 0.35 3 |
| Serum HBcAb (S/CO) | 8.51 (8.17, 8.8) | 8.8 (8.24, 9.31) | 0.17 3 |
| Serum HBV DNA (log10 IU/mL) | 3.74 (2.84, 6.71) | 4.76 (2.86, 6.91) | 0.42 3 |
Disclaimer/Publisher’s Note: The statements, opinions and data contained in all publications are solely those of the individual author(s) and contributor(s) and not of MDPI and/or the editor(s). MDPI and/or the editor(s) disclaim responsibility for any injury to people or property resulting from any ideas, methods, instructions or products referred to in the content. |
© 2025 by the authors. Licensee MDPI, Basel, Switzerland. This article is an open access article distributed under the terms and conditions of the Creative Commons Attribution (CC BY) license (https://creativecommons.org/licenses/by/4.0/).
Share and Cite
Zheng, Y.; Tong, H.; Guo, W.; Wang, A.; Hu, W.; Wu, M.; Zhang, X. C4d Immunoreactivity in Autoimmune and HBV-Induced Hepatitis: Implications for Complement-Mediated Hepatocellular Injury. Pathophysiology 2025, 32, 30. https://doi.org/10.3390/pathophysiology32030030
Zheng Y, Tong H, Guo W, Wang A, Hu W, Wu M, Zhang X. C4d Immunoreactivity in Autoimmune and HBV-Induced Hepatitis: Implications for Complement-Mediated Hepatocellular Injury. Pathophysiology. 2025; 32(3):30. https://doi.org/10.3390/pathophysiology32030030
Chicago/Turabian StyleZheng, Ye, Haitao Tong, Wenjuan Guo, Ao Wang, Wenxing Hu, Min Wu, and Xiaonan Zhang. 2025. "C4d Immunoreactivity in Autoimmune and HBV-Induced Hepatitis: Implications for Complement-Mediated Hepatocellular Injury" Pathophysiology 32, no. 3: 30. https://doi.org/10.3390/pathophysiology32030030
APA StyleZheng, Y., Tong, H., Guo, W., Wang, A., Hu, W., Wu, M., & Zhang, X. (2025). C4d Immunoreactivity in Autoimmune and HBV-Induced Hepatitis: Implications for Complement-Mediated Hepatocellular Injury. Pathophysiology, 32(3), 30. https://doi.org/10.3390/pathophysiology32030030

